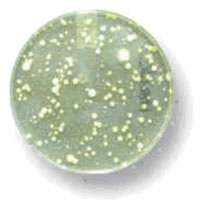

El documento Análisis de compuestos orgánicos volátiles en el aire de los lugares de trabajo, derivado de un póster presentado en el XII Congreso Nacional de Seguridad y Salud en el Trabajo (Valencia 20-23 de noviembre de 2001), describe una nueva metodología de calibración química para mejorar la calidad de los resultados obtenidos en este tipo de estudios.
En concreto, este procedimiento se basa en un control global por gravimetría de los procesos de preparación de patrones de calibración y en la preparación de dichos patrones de calibración en el disolvente de desorción y en el propio adsorbente.
Etapas del proceso de validación:
- Preparación de una calibración de Benceno, Tolueno, m-Xileno y Tricloroetileno en S2C conteniendo n-Propilbenceno como patrón interno en concentración de 1 ?l/ml preparado por volumetría.
- Repetición de la experiencia anterior controlando el patrón interno por gravimetría.
- Preparación para los mismos compuestos de dos calibraciones en S2C y en carbón activo/S2C.
En el resumen se muestran las figuras gráficas correspondientes.
Como conclusiones del estudio se desprende que el control gravimétrico garantiza la trazabilidad de las concentraciones y de los resultados cuantitativos obtenidos. Además, y entre otros, se demuestra que la utilización simultánea de distintos patrones internos en la preparación de muestras reales permite una metodología individualizada de detección de errores.
Nota: extracto de Análisis de compuestos orgánicos volátiles en el aire de los lugares de trabajo. Desarrollo de una nueva herramienta analítica para la mejora de la calidad de los resultados, de J. F. López Arbeloa y M. Adrián Rojo (Centro Nacional de Verificación de Maquinaria).



